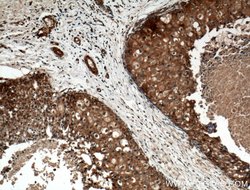
MCP1 Rabbit anti-Human, Polyclonal, Proteintech 150 &mu;L; Unconjugated:Antibodies,
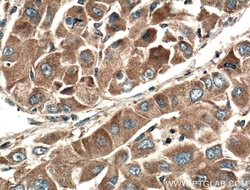
MCP1 Rabbit anti-Human, Polyclonal, Proteintech 150 &mu;L; Unconjugated:Antibodies,

missing translation for 'onlineSavingsMsg'
Learn More
Learn More
MCP1 Rabbit anti-Human, Polyclonal, Proteintech
Rabbit Polyclonal Antibody
Brand: Proteintech 25542-1-AP-150UL
This item is not returnable.
View return policy
Description
This chemotactic factor attracts monocytes and basophils but not neutrophils or eosinophils and augments monocyte anti-tumor activity. It has been implicated in the pathogenesis of diseases characterized by monocytic infiltrates, like psoriasis, rheumatoid arthritis or atherosclerosis. It may be involved in the recruitment of monocytes into the arterial wall during the disease process of atherosclerosis.Specifications
| MCP1 | |
| Polyclonal | |
| Unconjugated | |
| CCL2 | |
| C C motif chemokine 2, CCL2, chemokine (C C motif) ligand 2, GDCF 2, HC11, HSMCR30, MCAF, MCP 1, MCP1, Monocyte chemotactic protein 1, Monocyte secretory protein JE, SCYA2, Small inducible cytokine A2, SMC CF | |
| Rabbit | |
| Antigen Affinity Chromatography | |
| RUO | |
| 6347 | |
| -20°C | |
| Liquid |
| Flow Cytometry, Immunocytochemistry, Immunofluorescence, Immunohistochemistry (Paraffin), Western Blot | |
| 0.29 mg/mL | |
| PBS with 50% glycerol and 0.1% sodium azide; pH 7.3 | |
| P13500 | |
| CCL2 | |
| MCP1 Fusion Protein Ag10601 | |
| 150 μL | |
| Primary | |
| Human | |
| Antibody | |
| IgG |
Product Content Correction
Your input is important to us. Please complete this form to provide feedback related to the content on this product.
Product Title
Spot an opportunity for improvement?Share a Content Correction